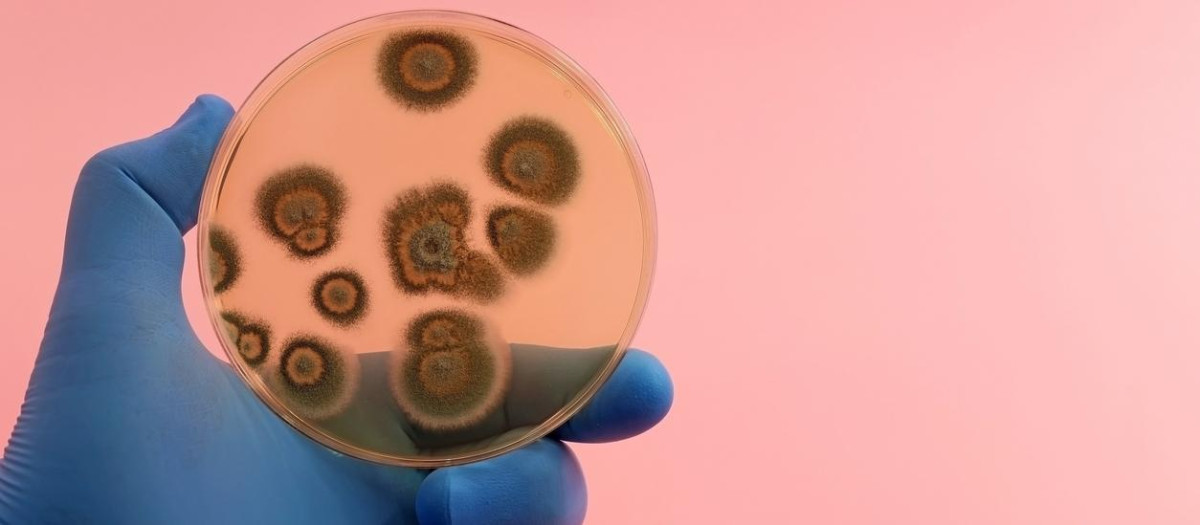
Fungal colonies isolated in the scientific research laboratory on a Petri dish

La albúmina, pieza clave en la defensa del cuerpo frente a la mucormicosis
La albúmina, pieza clave en la defensa del cuerpo frente a infecciones por hongos
La contribución de la Universidad CEU San Pablo ha sido clave para desentrañar los mecanismos metabólicos subyacentes
Un grupo internacional de científicos ha descubierto un mecanismo clave de defensa inmunitaria frente a la mucormicosis, una infección fúngica severa y potencialmente letal que afecta de forma especial a personas con trastornos metabólicos. Los hallazgos, publicados en la revista Nature, han sido liderados por el profesor Georgios Chamilos, al frente del Laboratorio de Microbiología Clínica y Patogénesis Microbiana en la Facultad de Medicina de la Universidad de Creta. Según sus conclusiones, la albúmina, la proteína más abundante en el torrente sanguíneo humano, desempeña un papel activo en la respuesta del organismo frente a hongos del orden Mucorales, más allá de su uso habitual como indicador clínico del estado general del paciente.
En concreto, el estudio revela que la albúmina influye directamente en la regulación, estabilidad y acción antifúngica de los ácidos grasos libres, modificando así la virulencia del patógeno. De este modo, se convierte en un elemento esencial en la respuesta inmunitaria frente a la mucormicosis.
La albúmina, la proteína más abundante en el torrente sanguíneo humano
La investigación ha contado con la participación de especialistas de al menos ocho países —Grecia, España, Francia, Bélgica, Alemania, Estados Unidos, India y China—, lo que refleja el alcance global del desafío sanitario que representa esta infección.
Uno de los pilares del descubrimiento ha sido la colaboración del Centro de Metabolómica y Bioanálisis (CEMBIO) de la Universidad CEU San Pablo, que ha permitido arrojar luz sobre los mecanismos metabólicos implicados en esta nueva forma de defensa inmunológica. Las científicas Coral Barbas, Ángeles López-López y Sandra Camuñas han empleado avanzadas técnicas de análisis lipidómico para demostrar que la capacidad antifúngica de la albúmina está ligada a los ácidos grasos libres que transporta y al estado químico de estos lípidos.
Tres hallazgos clave
Así, el equipo ha identificado tres hallazgos clave:
- Los ácidos grasos libres en su forma no oxidada ejercen una potente acción inhibidora sobre el crecimiento de Mucorales.
- La albúmina cumple una función protectora, evitando que estos lípidos se oxiden y conserven su eficacia antifúngica.
- En pacientes que padecen mucormicosis, se observan altos niveles de ácidos grasos oxidados, una situación que coincide con la presencia de hipoalbuminemia y una pérdida de la actividad protectora del suero.
Estos resultados establecen un vínculo directo entre el deterioro metabólico, el estrés oxidativo y una mayor vulnerabilidad a esta infección, proporcionando así una base científica sólida para observaciones clínicas previas.
El alcance clínico del estudio es notable. Los investigadores han podido confirmar que los niveles bajos de albúmina en sangre están asociados a un peor pronóstico en pacientes con mucormicosis. En consecuencia, plantean que el tratamiento de la hipoalbuminemia podría convertirse en una estrategia preventiva y terapéutica complementaria, particularmente eficaz en pacientes con alto riesgo de desarrollar esta infección.
El estudio redefine la visión tradicional de la albúmina, situándola no solo como biomarcador del estado del paciente, sino como un agente inmunomodulador con impacto directo en la lucha contra infecciones micóticas graves. A raíz de estos resultados, el equipo investigador aspira a dar el siguiente paso y promover un ensayo clínico en el que se evalúe el uso terapéutico de la albúmina en pacientes afectados por mucormicosis con niveles bajos de esta proteína, con el objetivo de mejorar sus perspectivas clínicas.




